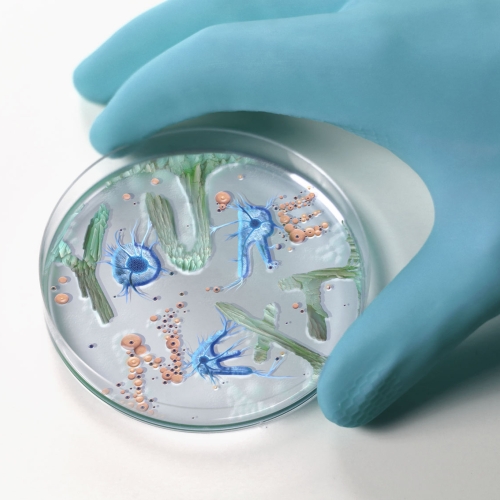
Typographic Bacteria

Description 2
Xavier Segers is an award-winning illustrator and graphic designer based in London.
His work is heavily inspired by his love for nature, surrealism and human connections.
His artwork and designs invoke wonder through his intricate and playful style.
His work is heavily inspired by his love for nature, surrealism and human connections.
His artwork and designs invoke wonder through his intricate and playful style.